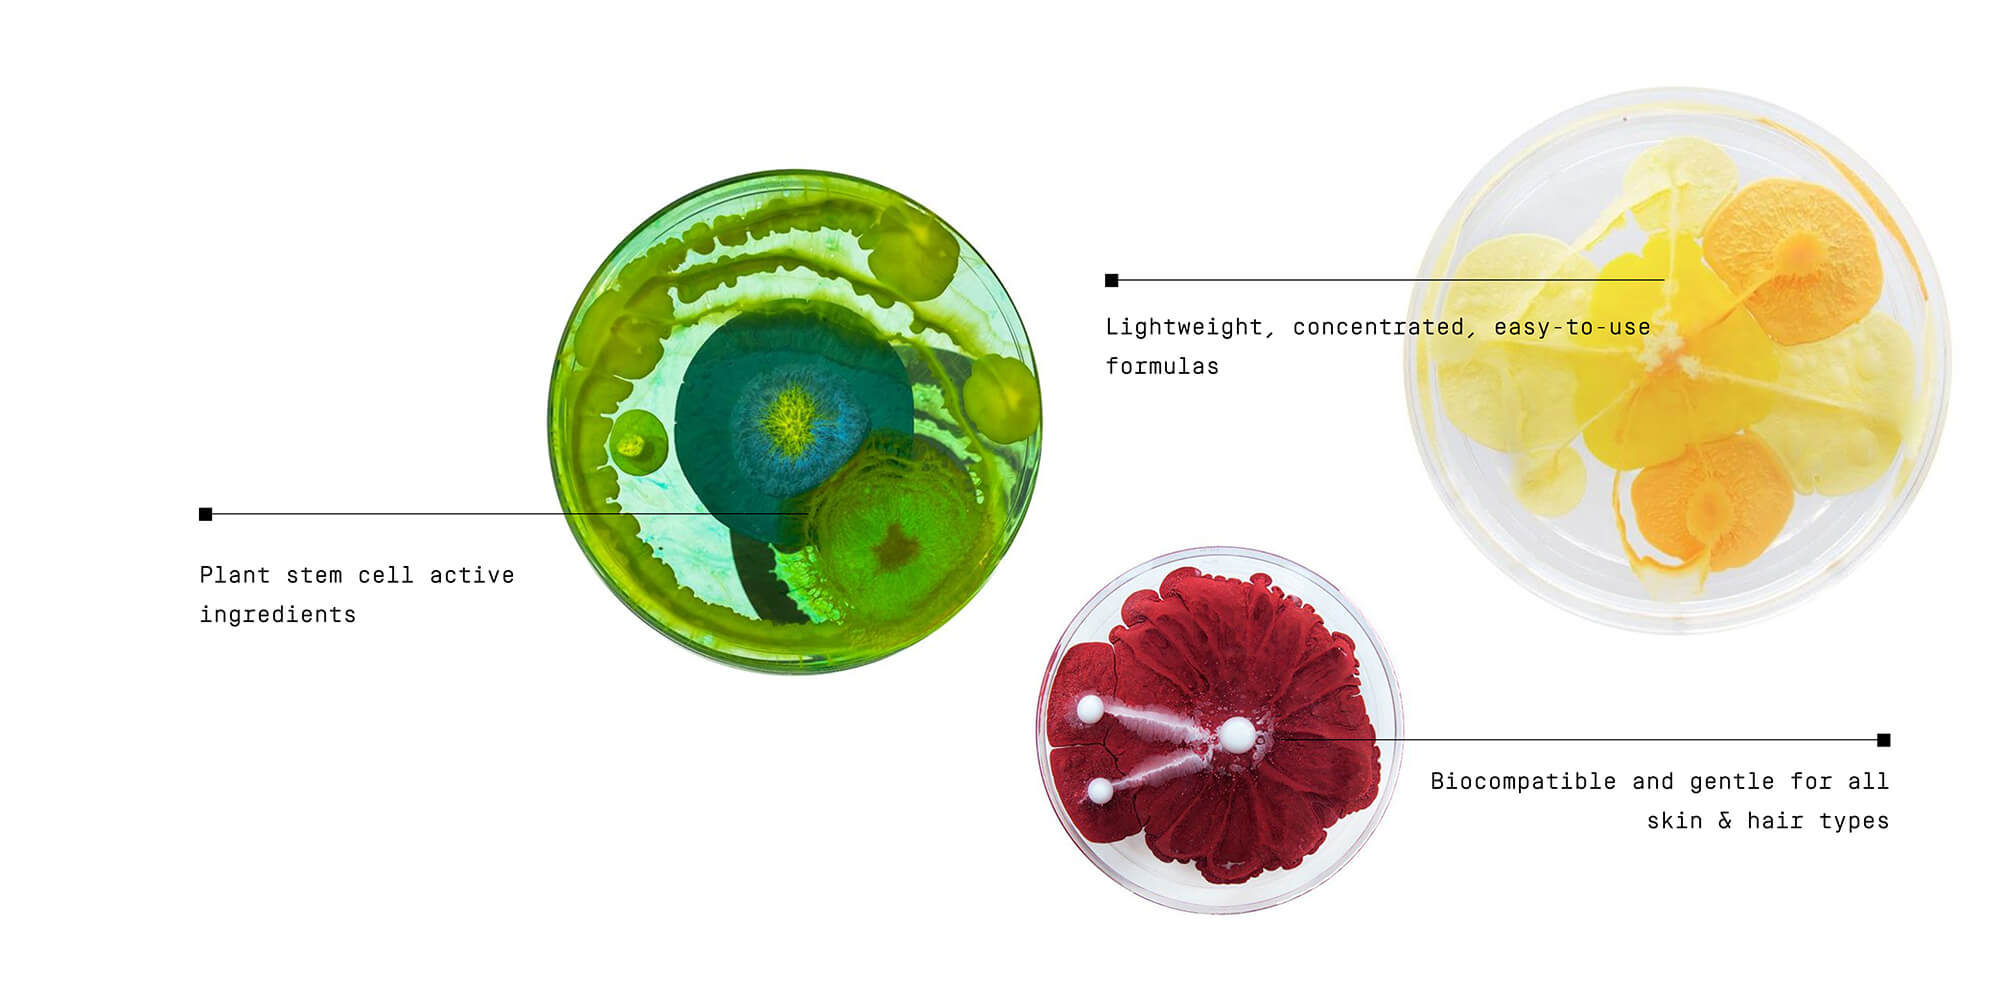

Next-Gen Sustainable Beauty
Next-Gen Sustainable Beauty
backed by science:
Patented plant stem cell active ingredients

Biocompatible and gentle for all skin & hair types

Lightweight, concentrated, easy-to-use formulas

Best Sellers:


Hair Routine
Strenghthens, hydrates & protects


Hair Essentials Set
Detoxifies & nourishes


Shampoo 00.01
Strengthening & stimulating


Leave-in Hair Cream 00.05
Intense molecular treatment


Scalp Activation Serum 00.32
Stimulates hair growth


Body Balm 00.14
Hydrates & barrier repair


Face Essentials Set
Brightening & repairing


Face Serum 00.25
Brightening & hydrating


Face Cream 00.26
Repairs, hydrates & calms
Unlocking the true power
of nature:

Patented bio-tech active ingredients with clinically proven efficacy.

Sustainable Production.
99% less land and
water used in
biotech actives

+90% Natural Origin Ingredients.
Safe and biocompatible for all skin & hair types
New in:


Curl Cream 00.07
Defined & protected curls


Scalp Detox Routine
Shampoo, Scalp Scrub, Scalp Serum, FREE Scalp Brush




Face Toner 00.24
Hydrates, renews, and reveals glass skin.


REDEFINING THE BEAUTY INDUSTRY
A next-gen clean beauty brand built around science,
creativity, and results.
Reviews:
Testimonials:
#usingmidnight















